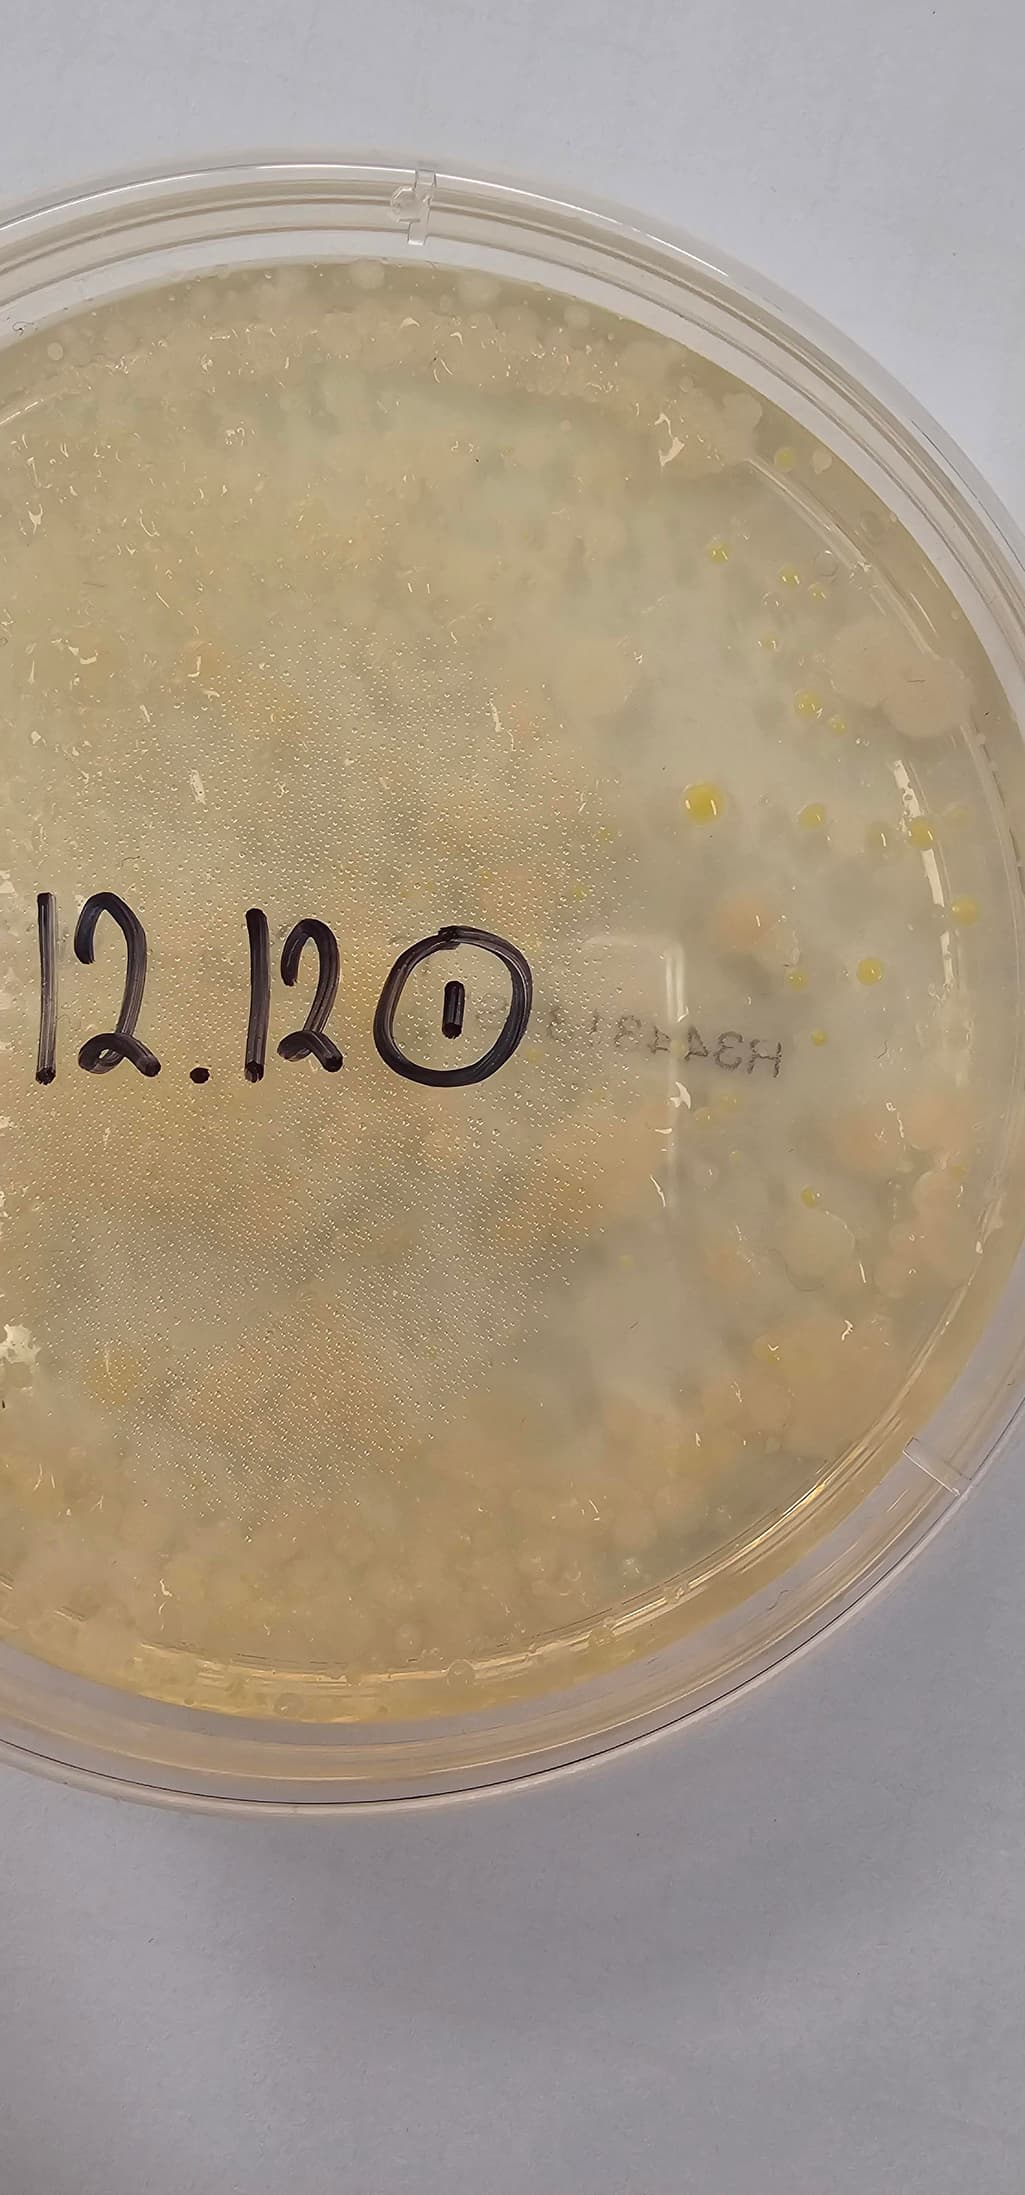

미생물 플라스틱 분해 실험 결과에서 곰팡이가 올라왔는데 얘는 무슨 역할인가요?
플라스틱 조각을 사포로 갈아서 증류수에 넣고 교반기를 이용해 열을 가해서 끓였습니다. 가루가 거의 다 녹은 모습을 확인하고 스프레이를 이용해 배지에 얇게 깔았습니다. 이후 마당에서 흙을 구해 흙탕물을 만든 후, 흙탕물 또한 스프레이를 이용해 깔아줬습니다. 그리고 실온 이상의 온도에서 보관한 후 최종 결과를 아하에 올렸더니, 하얀색 곰팡이가 올라오고 흙 속 미생물이 플라스틱을 분해하면서 성장한 노란색 세균이 올라온 모습이라고 한 전문가님의 답변을 받았습니다. 노란색 세균이 플라스틱을 분해하는 역할을 맡고있는 건 알겠지만 하얀색 곰팡이는 그냥 자연적으로 생긴걸까요? 아니면 하얀색 곰팡이도 무슨 중요한 역할을 하는건가요? 자세한 답변 부탁드립니다.
안녕하세요. 김찬우 전문가입니다.
음 미생물전공은 아니긴 하지만 의문점이 드는게 있습니다.
플라스틱이 혹시 PLA 같은 생분해성 플라스틱 인가요? 일반 플라스틱은 잘게 잘라서 외부 흙과 교반시켜 실온에 보관해도 미생물에 의해 분해가 일어나지 않기 때문입니다.
하지만 PLA 같은 생분해성 플라스틱이라면 분해가 일어날 수 있습니다. 하얀색 곰팡이와 노란색 세균 이 발견되는 것 같은데 땅속에는 여러종류의 곰팡이가 존재하기 때문에 어떤 종류이고 어떤 특성을 가지고 있는지는 실제로 분석기관에 맡겨야지 판단이 될 것 같습니다.
곰팡이는 뭔가 제거해야될 물질로 생각하지만 땅속의 곰팡이는 생태계 균형을 이루는 필수 적인 존재로 육지 식물의 뿌리는 대부분 곰팡이와 공생관계를 맺고 있다고 생각하시면 될정도 중요한 존재 이기 때문입니다.
그럼 답변 읽어주셔서 감사드립니다~! 더 궁금한게 있으시면 언제든지 문의 주십시요:)
1명 평가
장도연이 추천하는 아하!
앱으로 편리하게 사용해 보세요.
장도연이 추천하는 아하!
앱으로 편리하게 사용해 보세요.